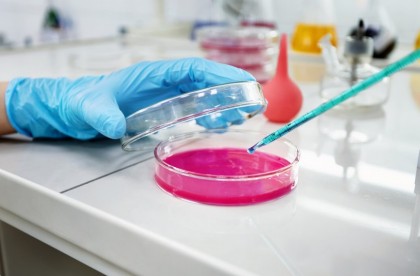
Studiu: biopsia lichidă care poate identifica cancerul endometrial

Studiu: biopsia lichidă care poate identifica cancerul endometrial
Cancerul endometrial este una dintre cele mai des întâlnite forme de cancer la femei, ale cărui statistici cresc îngrijorător la nivel global. În prezent, acest tip de cancer este diagnosticat cu ajutorul procedurilor medicale chirurgicale, cum ar fi biopsii de țesut, care vin alături de nevoia de recuperare pentru pacientă și care se pot dovedi neconclusive în anumite cazuri.
Cercetătorii de la Universitatea de Medicină din Varșovia au organizat un studiu prin care se urmărea testarea lichidă, prin analize de sânge, dedicate femeilor suspecte de cancer endometrial.
Studiul „Diagnosticarea cancerului endometrial prin biopsie lichidă” arată cum cercetătorii au explorat ideea studierii unei biopsii lichide – prin analiza sângelui în loc de țesut. Scopul analizei sângelui este de a identifica fragmente moleculare de cancer prezente în sânge. (1)
Studiul se concentrează pe două premise. Prima premiză se concentrază pe plachetele sanguine influențate de tumoră (tumor-educated platelets / TEPs). Aceste plachete sunt plachete sanguine obișnuite, dar al căror profil ARN se modifică atunci când cancerul este prezent în corp. (2)
A două ipoteză studiază ADN-ul tumoral circulant (ctADN), fiind fragmente microscopice de ADN eliberate în sânge de celulele canceroase. (3)
Studiul a inclus analize de sânge de la aproape 300 de femei. Plachetele sanguine influențate de tumoră au fost studiate de la: 53 de femei diagnosticate cu cancer endometrial, 38 de paciente cu afecțiuni ginecologice benigne și de la 204 femei clinic sănătoase.
De asemenea, ADN-ul tumoral circulant a fost studiat în 519 probe biologice de la femeile implicate în studiu și din 16 probe de plasmă.
Ulterior, inteligența artificială și tehnici de secvențiere avansată au fost folosite pentru a clasifica probele, în funcție de datele extrase din biopsiile lichide.
Testele plachetelor sanguine influențate de tumoră au identificat cu succes pacientele sănătoase de cele bolnave de cancer cu o acuratețe de peste 97%. În ceea privește diferețierea pacientelor bolnave de cancer de cele cu afecțiuni ginecologice benigne studiul a înregistrat rezultate promițătoare, cu o acuratețe de 84%.
A doua metodă care a presupus testarea ADN-ul tumoral circulant a oferit rezultate satisfăcătoare. În țesutul primar (nu din sânge), a avut o rată de identificare de 96%, dar în ceea ce privește analiza probelor din sânge (plasmă) a înregistrat o rată de succes de doar 69%.
Aceste biopsii lichide sunt înca în fază exploratorie, dar oferă o perspectivă medicală extrem de facilă – fiind în primul rând neinvazive, oferindu-le pacientelor șansa de a face un test care le poate salva viața.
(2) Lianidou E., Pantel K. Liquid Biopsies. Genes. Chromosom. Cancer. 2019;58:219–232. doi: 10.1002/gcc.22695, Liquid biopsies - Lianidou - 2019 - Genes, Chromosomes and Cancer - Wiley Online Library
(3) Best M.G., Sol N., Kooi I., Tannous J., Westerman B.A., Rustenburg F., Schellen P., Verschueren H., Post E., Koster J., et al. RNA-Seq of Tumor-Educated Platelets Enables Blood-Based Pan-Cancer, Multiclass, and Molecular Pathway Cancer Diagnostics. Cancer Cell. 2015;28:666–676. doi: 10.1016/j.ccell.2015.09.018, RNA-Seq of Tumor-Educated Platelets Enables Blood-Based Pan-Cancer, Multiclass, and Molecular Pathway Cancer Diagnostics: Cancer Cell
Image by wayhomestudio on Freepik
Copyright ROmedic: Articolul se află sub protecția drepturilor de autor. Reproducerea, chiar și parțială, este interzisă!
- Nivelul de cortizol din păr și riscul de tulburări psihopatologice la copiii cu boli cronice
- Biomarkeri din mucusul ecrvical ar putea ajuta la detectarea timpurie a cancerului cervical
- Sângele înmagazinat devine mai rigid odată cu trecerea timpului
- Un nou studiu relevă beneficiile testării acasă pentru sifilis
- Cancerul endometrial
- Posibilitatea depistării cancerelor gastrice asimptomatice prin intermediul biopsiei lichide
- Biopsia lichidă - utilă pentru depistarea bolnavilor cu răspuns favorabil la imunoterapie
- Biopsia lichidă înlocuiește biopsia tisulară în diagnosticarea cancerului pulmonar non-microcelular
- Neoplasm de endometru cu recidive in tesuturile moi si centrul oncofort
- Adenocarcinom endometrioid.. vă rog ce înseamnă acest diagnostic, cât este de grav?
- Cancer de endometru